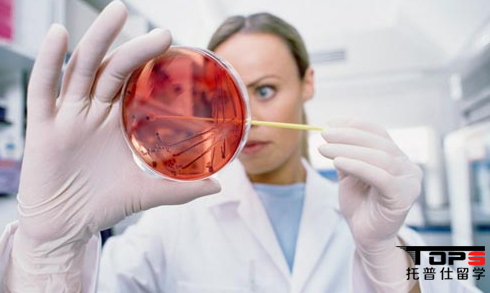
公共卫生.png

留学指南
专属申请
院校排名
录取案例
前招生官
海外顾问
背景提升
留学活动
学子反馈
关于我们
时间:2018-01-29 16:29:01浏览:5673
美国留学可选择的学科众多,今天托普仕留学老师带你认识一门日益受到各国的关注的专业——公共卫生专业。这个专业由于和人类生存发展都有着息息相关的联系。随着近年来全球不断爆发疾病灾害,对于流行性疾病传播的防控、政府相应政策的出台都需要公共卫生的专业人才。公共卫生专业毕业生可选择的就业范围是相当广的。从医疗机构,到政府机构,再到科研机构都有生存的空间。所以在近年来的美国留学过程中吸引了很多学生的目光。接下来我们就详细了解一下这门专业吧!
美国留学可选择的学科众多,今天托普仕留学老师带你认识一门日益受到各国的关注的专业——公共卫生专业。这个专业由于和人类生存发展都有着息息相关的联系。随着近年来全球不断爆发疾病灾害,对于流行性疾病传播的防控、政府相应政策的出台都需要公共卫生的专业人才。公共卫生专业毕业生可选择的就业范围是相当广的。从医疗机构,到政府机构,再到科研机构都有生存的空间。所以在近年来的美国留学过程中吸引了很多学生的目光。接下来我们就详细了解一下这门专业吧!
其实,并不是所有的美国大学都开设相关专业,目前,被美国公共卫生学会认证的一共有40 accredited schools of public health,其中包括12间私立学校和28间公立学校,由于很多美国公共卫生学院的前身都是从医学院中发展出来的,因此时至今日还有不少的Public Health是设置在医学院下面。

申请要求:
1. 背景要求
由于公共卫生的大部分专业与医学紧密相关,因此对于国际学生来说,如果具有一定医学背景,将大大增加被录取的几率。如果没有医学相关学位,申请者可以积极参与国内的公共卫生项目,如疾病的宣传教育课题等,这样可在一定程度上弥补背景的不足。
一般选择公共卫生专业 的学生,除了公卫本专业,临床,药学,护理,基础医学,营养学,生物,化学等专业学生可以选择申请外,事实上对于统计,数学等专业方面的申请者来说也是很好的选择。特别是生物统计和流行病学方向,需要用到统计学原理和软件去研究疾病,所以申请者不一定需要医学背景,但学校往往会要求学生在本科或者研究生阶段有一定的高等数学和统计学的课程。而这两个方向又是中国学生特别偏爱的方向,从而加大了竞争的激烈性。
2. 标准化考试
语言要求:目前美国TOP 100的学校,很多同时认可托福和雅思。因此也可以用雅思申请。一般来讲,IBT要达到80以上,TOP50的学校要求90左右。部分顶级学校会要求IBT 100 以上。建议考到90+。部分学校除了有总成绩要求外,还有单项要求,一般来讲,建议单项不低于18,最好单项都能到20以上。雅思通常需要考到6.5以上,单项不低于6,部分学校会要求雅思达到7分。
GRE考试:大部分学校不会明确给出GRE的最低要求,按照往年的录取情况,310-320算是比较有竞争力的区间。高于320视为非常优秀,最低也建议达到300以上。
3. GPA要求
3.0, 这个是美国大学硕士申请的基本GPA要求,如果未达到3.0以上则被视为申请当中的背景硬伤。在这种情况下,很容易因为绩点的问题被学校直接拒掉。如果GPA达到3.5以上,则可以认为在GPA方面具有一定的优势。
4. 文书材料
PS,CV,推荐信,ESSAYS对于申请者来说,很重要,一定要把个人的特色和优点展示给学校招生官,获得招生官的青睐,拿到面试机会,最终通过面试中的优秀表现,获得学校的录取。

美国大学公共卫生专业院校排名TOP30
| 排名 | 学校 | 学校英文 | 得分 |
| 1 | 约翰霍普金斯大学 | Johns Hopkins University | 4.8 |
| 2 | 北卡罗来纳大学教堂山分校 | University of North Carolina–Chapel Hill | 4.6 |
| 3 | 哈佛大学 | Harvard University | 4.5 |
| 4 | 密歇根大学安娜堡分校 | University of Michigan,Ann Arbor | 4.3 |
| 5 | 哥伦比亚大学 | Columbia University | 4.2 |
| 6 | 艾茉莉大学 | Emory University | 4.1 |
| 6 | 华盛顿大学 | University of Washington | 4.1 |
| 8 | 加州大学伯克利分校 | University of California–Berkeley | 3.8 |
| 8 | 明尼苏达大学双城分校 | University of Minnesota–Twin Cities | 3.8 |
| 10 | 加州大学洛杉矶分校 | University of California–Los Angeles | 3.7 |
| 11 | 波士顿大学 | Boston University | 3.4 |
| 11 | 匹兹堡大学 | University of Pittsburgh | 3.4 |
| 13 | 杜兰大学 | Tulane University | 3.3 |
| 13 | 耶鲁大学 | Yale University | 3.3 |
| 15 | 德克萨斯休斯敦健康科学中心 | University of Texas–Houston Health Sciences Center | 3.2 |
| 16 | 乔治华盛顿大学 | George Washington University | 3.0 |
| 16 | 阿拉巴马大学伯明翰分校 | University of Alabama–Birmingham | 3.0 |
| 16 | 伊利诺伊大学芝加哥分校 | University of Illinois–Chicago | 3.0 |
| 16 | 爱荷华大学 | University of Iowa | 3.0 |
| 20 | 俄亥俄州立大学 | Ohio State University | 2.8 |
| 21 | 德雷塞尔大学 | Drexel University | 2.7 |
| 21 | 南佛罗里达大学 | University of South Florida | 2.7 |
| 23 | 亚利桑那大学 | University of Arizona (Zuckerman) | 2.5 |
| 23 | 南卡罗来纳大学哥伦比亚分校 | University of South Carolina | 2.5 |
| 25 | 德州农工健康科学中心 | Texas A&M Health Science Center | 2.4 |
| 25 | 纽约州立大学阿尔巴尼分校 | University at Albany–SUNY | 2.4 |
| 25 | 肯塔基大学 | University of Kentucky | 2.4 |
| 25 | 俄克拉荷马大学 | University of Oklahoma | 2.4 |
| 29 | 佛罗里达大学 | University of Florida | 2.3 |
| 30 | 圣地亚哥州立大学 | San Diego State University | 2.2 |
| 30 | 新泽西理工学院 | UMDNJ-Rutgers-New Jersey Institute of Technology | 2.2 |
| 30 | 阿肯色大学医学中心 | University of Arkansas for Medical Sciences (Boozman) | 2.2 |
| 30 | 马里兰大学学院公园分校 | University of Maryland–College Park | 2.2 |